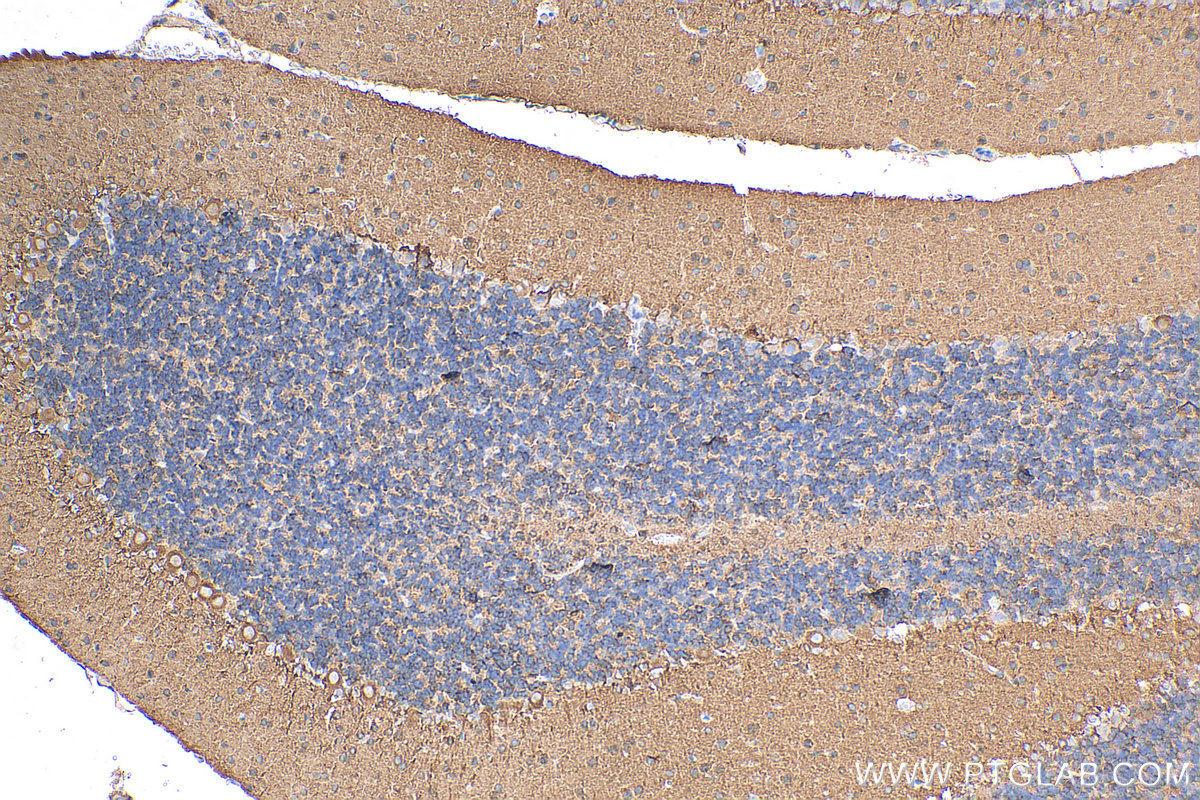

验证数据展示
经过测试的应用
| Positive WB detected in | HepG2 cells, HeLa cells |
| Positive IHC detected in | rat cerebellum tissue Note: suggested antigen retrieval with TE buffer pH 9.0; (*) Alternatively, antigen retrieval may be performed with citrate buffer pH 6.0 |
推荐稀释比
| 应用 | 推荐稀释比 |
|---|---|
| Western Blot (WB) | WB : 1:500-1:1000 |
| Immunohistochemistry (IHC) | IHC : 1:50-1:500 |
| It is recommended that this reagent should be titrated in each testing system to obtain optimal results. | |
| Sample-dependent, Check data in validation data gallery. | |
产品信息
55125-1-AP targets PTPRZ1 in WB, IHC, IF, ELISA applications and shows reactivity with human, mouse, rat samples.
| 经测试应用 | WB, IHC, ELISA Application Description |
| 文献引用应用 | WB, IHC, IF |
| 经测试反应性 | human, mouse, rat |
| 文献引用反应性 | human, mouse, rat |
| 免疫原 |
Peptide 种属同源性预测 |
| 宿主/亚型 | Rabbit / IgG |
| 抗体类别 | Polyclonal |
| 产品类型 | Antibody |
| 全称 | protein tyrosine phosphatase, receptor-type, Z polypeptide 1 |
| 别名 | EC:3.1.3.48, HPTPZ, HTPZP2, Protein-tyrosine phosphatase receptor type Z polypeptide 1, Protein-tyrosine phosphatase receptor type Z polypeptide 2 |
| 计算分子量 | 255 kDa |
| 观测分子量 | 163-175 kDa |
| GenBank蛋白编号 | NM_002851 |
| 基因名称 | PTPRZ1 |
| Gene ID (NCBI) | 5803 |
| RRID | AB_10858795 |
| 偶联类型 | Unconjugated |
| 形式 | Liquid |
| 纯化方式 | Antigen affinity purification |
| UNIPROT ID | P23471 |
| 储存缓冲液 | PBS with 0.02% sodium azide and 50% glycerol, pH 7.3. |
| 储存条件 | Store at -20°C. Stable for one year after shipment. Aliquoting is unnecessary for -20oC storage. |
背景介绍
PTPRZ1, also named as HTPZP2, PTPRZ, PTPRZ2 and PTPZ, belongs to the protein-tyrosine phosphatase family and Receptor class 5 subfamily. It may be involved in the regulation of specific developmental processes in the CNS. PTPRZ1 has some isoforms with MW 254 kDa, 163 kDa and 90 kDa.(PMID: 35457233; 31205522)
实验方案
| Product Specific Protocols | |
|---|---|
| IHC protocol for PTPRZ1 antibody 55125-1-AP | Download protocol |
| WB protocol for PTPRZ1 antibody 55125-1-AP | Download protocol |
| Standard Protocols | |
|---|---|
| Click here to view our Standard Protocols |
发表文章
| Species | Application | Title |
|---|---|---|
J Clin Invest Sec13 promotes oligodendrocyte differentiation and myelin repair through autocrine pleiotrophin signaling. | ||
J Ethnopharmacol Echinacoside targets the HIF-1α/LDHA axis to modulate A1/A2 astrocyte differentiation and promote glial scar repair following ischemic stroke | ||
J Oncol Overexpression of PTPRZ1 Regulates p120/β-Catenin Phosphorylation to Promote Carcinogenesis of Oral Submucous Fibrosis. | ||
Heliyon IL-34 and its receptors as predictors of brain metastasis and prognosis in lung adenocarcinoma: Unveiling insights through bioinformatic and immunohistochemical investigations | ||
Rapid Commun Mass Spectrom Data-independent acquisition combined with liquid chromatography mass spectrometry technique to detect prognostic protein markers in type I gastric neuroendocrine neoplasm | ||
iScience Single-nucleus RNA sequencing-based construction of a hippocampal neuron atlas in mice with epileptic cognitive impairment |